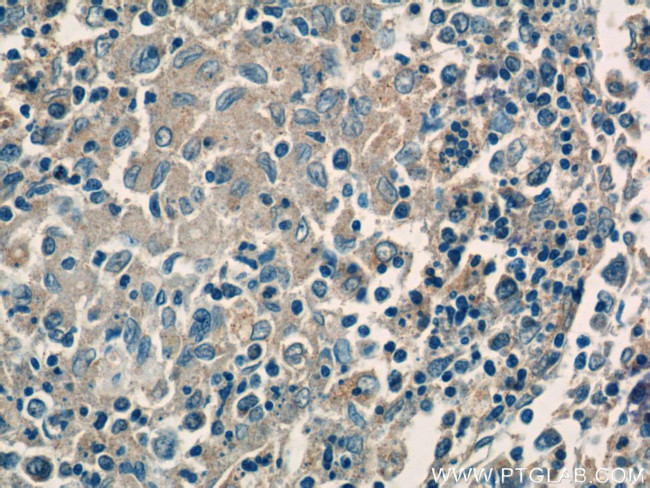
CFP Antibody in Immunohistochemistry (Paraffin) (IHC (P))

Search
Proteintech
CFP Polyclonal Antibody
{{$productOrderCtrl.translations['antibody.pdp.commerceCard.promotion.promotions']}}
{{$productOrderCtrl.translations['antibody.pdp.commerceCard.promotion.viewpromo']}}
{{$productOrderCtrl.translations['antibody.pdp.commerceCard.promotion.promocode']}}: {{promo.promoCode}} {{promo.promoTitle}} {{promo.promoDescription}}. {{$productOrderCtrl.translations['antibody.pdp.commerceCard.promotion.learnmore']}}
产品信息
17192-1-AP
种属反应
宿主/亚型
分类
类型
抗原
偶联物
形式
浓度
规格
纯化类型
保存液
内含物
保存条件
运输条件
产品详细信息
Immunogen sequence: LEWQLQACE DQQCCPEMGG WSGWGPWEPC SVTCSKGTRT RRRACNHPAP KCGGHCPGQA QESEACDTQQ VCPTHGAWAT WGPWTPCSAS CHGGPHEPKE TRSRKCSAPE PSQKPPGKPC PGLAYEQRRC TGLPPCPVAG GWGPWGPVSP CPVTCGLGQT MEQRTCNHPV PQHGGPFCAG DATRTHICNT AVPCPVDGEW DSWGEWSPCI RRNMKSISCQ EIPGQQSRGR TCRGRKFDGH RCAGQQQDIR HCYSIQHCPL KGSWSEWSTW GLCMPPCGPN PTRARQRLCT PLLPKYPPTV SMVEGQGEKN VTFWGRPLPR CEELQGQKLV VEEKRPCLHV PACKDPEEEE L (120-469 aa encoded by BC015756)
靶标信息
This gene encodes a plasma glycoprotein that positively regulates the alternative complement pathway of the innate immune system. This protein binds to many microbial surfaces and apoptotic cells and stabilizes the C3- and C5-convertase enzyme complexes in a feedback loop that ultimately leads to formation of the membrane attack complex and lysis of the target cell. Mutations in this gene result in two forms of properdin deficiency, which results in high susceptibility to meningococcal infections.
仅用于科研。不用于诊断过程。未经明确授权不得转售。
生物信息学
蛋白别名: Bf; C3 Proaccelerator; C3/C5 convertase; cfb; Complement factor P; GBG; H2-Bf; PBF2; Properdin; properdin P factor, complement; unnamed protein product
基因别名: BFD; CFP; PFC; PFD; PROPERDIN
UniProt ID: (Human) P27918
Entrez Gene ID: (Human) 5199